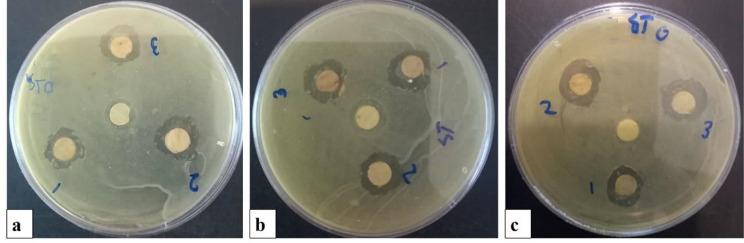
https://cdn.ncbi.nlm.nih.gov/pmc/blobs/dc1f/12046962/e6a4b6a5ee50/12866_2025_3975_Fig7_HTML.jpg

研究基于磁场提取藻蓝蛋白的生物基传感器包装对感染金黄色葡萄球菌的鱼片货架期的影响。
Studying the effect bio-based sensorns packaging based on magnetic fields extraction of phycocyanin on the shelf life of fish fillets infected with Staphylococcus aureus.
作者信息
Nowruzi Bahareh, Ghorbani Mahshid, Ghane Maryam, Ashrafizadeh Mahrokh, Barandak Rojan, Targholizadeh Melika
机构信息
Department of Biology, SR.C, Islamic Azad University, Tehran, Iran.
Department of Biology, Islamshahr Branch, Islamic Azad University, Islamshahr, Iran.
出版信息
BMC Microbiol. 2025 May 2;25(1):263. doi: 10.1186/s12866-025-03975-9.
Fish and seafood are highly perishable commodities, necessitating innovative packaging solutions to mitigate microbial spoilage and extend shelf life. This study developed a bioactive nanocomposite biosensor incorporating phycocyanin (PC) a pigment extracted from Neowestiellopsis persica and functionalized under 30 and 60 Millitesla (mT) magnetic fields (MF) coated with nanochitosan (NCT)- Sodium Alginate (SA). Reaults showed that MF exposure enhanced PC purity and concentration by 1.04- and 1.12-fold, respectively (p < 0.05), compared to non-MF controls. Agar disk diffusion assays revealed a 1.12-fold (30 mT) and 1.15-fold (60 mT) increase in antibacterial activity against Staphylococcus aureus. Films containing 2% PC (T4) extended shelf life by 8 days under refrigeration, reducing thiobarbituric acid (TBA) and total volatile nitrogen (TVN) levels to 18.85 ± 0.39 mg MDA/kg and < 30 mg/100 g, respectively, over 15 days. Furthermore, T4 significantly suppressed microbial proliferation relative to lower-concentration treatments and controls (p < 0.05). These results demonstrate that MF-enhanced, 2% PC nanocomposites provide a sustainable, biodegradable solution for seafood preservation, effectively delaying spoilage and advancing innovative packaging technologies.
鱼类和海鲜是极易腐坏的商品,因此需要创新的包装解决方案来减轻微生物腐败并延长保质期。本研究开发了一种生物活性纳米复合生物传感器,其包含从波斯新角藻中提取的藻蓝蛋白(PC),并在30和60毫特斯拉(mT)的磁场(MF)下进行功能化处理,然后用纳米壳聚糖(NCT)-海藻酸钠(SA)进行包覆。结果表明,与非MF对照相比,暴露于MF分别使PC的纯度和浓度提高了1.04倍和1.12倍(p < 0.05)。琼脂扩散试验显示,对金黄色葡萄球菌的抗菌活性提高了1.12倍(30 mT)和1.15倍(60 mT)。含有2% PC的薄膜(T4)在冷藏条件下使保质期延长了8天,在15天内将硫代巴比妥酸(TBA)和总挥发性氮(TVN)水平分别降低至18.85±0.39毫克丙二醛/千克和<30毫克/100克。此外,与低浓度处理和对照相比,T4显著抑制了微生物增殖(p < 0.05)。这些结果表明,MF增强的2% PC纳米复合材料为海鲜保鲜提供了一种可持续的、可生物降解的解决方案,有效地延缓了腐败并推动了创新包装技术的发展。